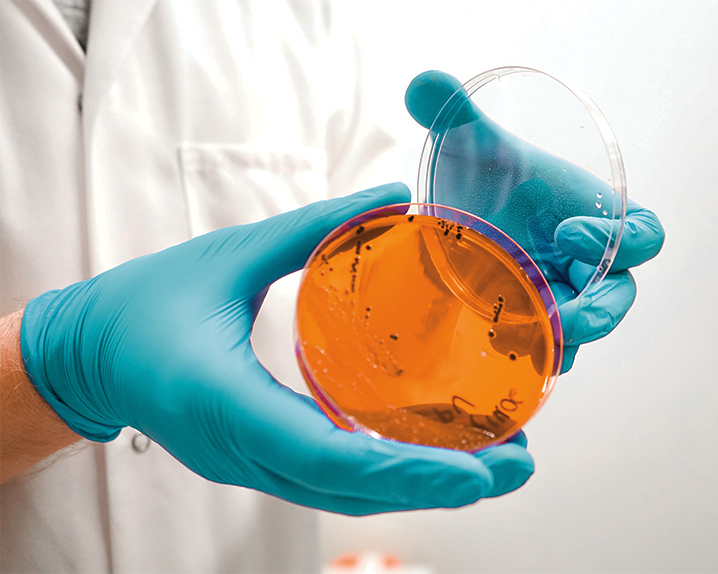

In India’s rapidly evolving food processing industry, maintaining stringent hygiene and safety standards is crucial—not just for consumer protection but also for global trade compliance. As India emerges as a major hub for food production and export, Environmental Monitoring Programs (EMPs) are becoming indispensable tools for ensuring food safety, complying with regulations, and preserving brand trust.

Image Reference: www.foodreadyai.com
What is an Environmental Monitoring Program (EMP)?
An Environmental Monitoring Program (EMP) is a structured protocol that involves systematic sampling and microbiological testing of a food facility’s environment—such as surfaces, equipment, air, water, and drains—to detect the presence of pathogens and hygiene indicators. EMPs help evaluate whether Good Manufacturing Practices (GMPs) and sanitation procedures are effective.
In India, where diverse climate conditions, infrastructure variability, and operational scale pose unique challenges, a well-designed EMP is vital for controlling contamination risks.
Why EMPs are Critical in Indian Food Facilities
1. Regulatory Compliance with FSSAI Guidelines
The FSSAI, under the Food Safety and Standards Act, 2006, mandates food businesses to implement preventive controls. EMPs form an integral part of this strategy. The Food Safety Management System (FSMS) documentation required by FSSAI includes provisions for monitoring the processing environment to ensure food safety compliance.
Specific sectors like dairy, seafood, ready-to-eat (RTE) foods, and meat processing are particularly under regulatory focus, making EMPs essential for license renewal and audit readiness.
2. Support for Export and International Standards
India exports significant quantities of food products globally. Meeting standards set by bodies like Codex Alimentarius, ISO 22000, BRCGS, and FSSC 22000 is necessary for accessing international markets. A robust EMP demonstrates commitment to hygiene and food safety, often serving as a competitive advantage in global supply chains.
3. Prevention of Foodborne Illnesses
India continues to report outbreaks of foodborne diseases due to contamination in processing environments. EMPs play a preventive role by identifying sources of pathogens like Listeria monocytogenes, Salmonella spp., and E. coli before they compromise food products.
Image reference: www.foodprocessing.com
4. Brand Reputation and Consumer Trust
With growing consumer awareness and media scrutiny, food businesses in India cannot afford recalls or negative publicity. A functioning EMP supports consistent product safety and enhances public trust.
Key Components of an EMP in Indian Context
1. Facility Zoning and Risk Mapping
Food facilities should be divided into zones based on contamination risk:
- Zone 1: Direct contact surfaces (e.g., conveyor belts, cutting blades)
- Zone 2: Close proximity (e.g., machine surfaces near food)
- Zone 3: Distant areas (e.g., floors, drains)
- Zone 4: Non-production areas (e.g., washrooms, offices)
Sampling plans must prioritise Zone 1 and Zone 2 in high-risk operations such as RTE food production.
2. Target Microorganisms
Microorganisms selected for monitoring depend on the nature of the product and environment:
- Listeria spp.: In chilled foods and dairy
- Salmonella spp.: In meat, poultry, and spices
- E. coli, coliforms, and total plate count: As hygiene indicators
FSSAI encourages use of microbiological criteria as per FSSR (Food Safety and Standards Regulations) 2011 and subsequent amendments.
3. Sampling Tools and Frequency
Sampling tools include:
- Sterile swabs or sponges
- Air samplers
- Settle plates
- Water testing kits
Frequency should be based on risk level. For high-risk areas, weekly or daily sampling is advised; lower-risk zones may be tested monthly.

Image reference: www.foodprocessing.com
4. Use of Accredited Laboratories
Samples should be tested in FSSAI-notified NABL-accredited labs for accurate results and regulatory acceptance. Modern rapid detection methods, such as RT-PCR or immunoassays, can supplement conventional culture methods.
5. Corrective and Preventive Actions (CAPA)
A positive finding must trigger:
- Immediate sanitation
- Root cause investigation
- Review of Standard Operating Procedures (SOPs)
- Staff retraining if needed
FSSAI audits may examine records of corrective actions during inspections.
6. Documentation and Trend Analysis
Indian food businesses are expected to maintain meticulous records under FSMS. EMP results should be documented and reviewed regularly to identify patterns and predict risk, enabling data-driven decisions.
EMP Implementation Challenges in India
Despite the benefits, several challenges hinder effective EMPs:
- Lack of awareness among small and medium enterprises (SMEs)
- Limited in-house microbiological expertise
- Budget constraints in rural and semi-urban facilities
- Inconsistent infrastructure and sanitation standards
Solutions include staff training, use of mobile testing labs, and partnerships with food safety consultants.
FSSAI’s Role and Initiatives
The FSSAI is actively working to promote environmental monitoring as part of a holistic food safety ecosystem. Key initiatives include:
- Training through FoSTaC (Food Safety Training and Certification)
- Sector-specific FSMS guidance documents (available on the FSSAI portal)
- Third-party audits and hygiene rating systems
- Encouragement of third-party EMP design and validation
These programs aim to raise awareness and help businesses—especially MSMEs—adopt good practices.
Conclusion
In India’s diverse and expanding food sector, Environmental Monitoring Programs are no longer a luxury—they are a necessity. A well-structured EMP not only fulfills regulatory obligations but also safeguards public health, builds consumer trust, and supports sustainable business growth.

